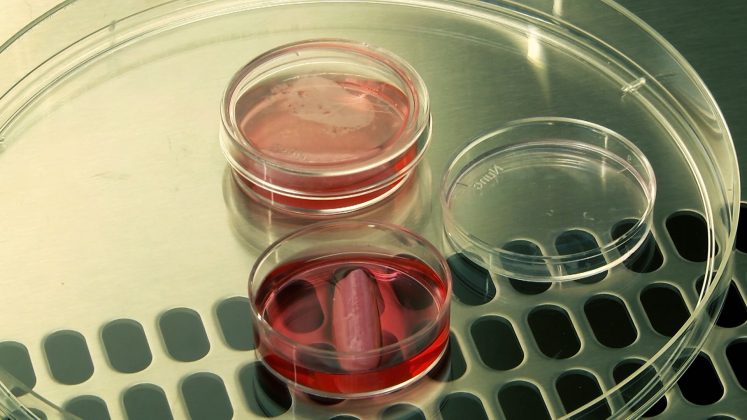

La final de an echipa de management a Centrului de Terapii Genice şi Celulare în tratamentul cancerului din cadrul Spitalului Clinic Județean de Urgență ,,Pius Brînzeu” Timișoara a ținut să scoată în evidență cele mai notabile evenimente ce au avut loc în acest institut.
Sarcină destul de complexă deoarece acolo în orice moment se întâmplă ceva de maximă importanță. Poate pentru timișoreanul obișnuit de pe strada e doar o clădire unde lucrează doctorii. E de fapt mult mai mult decât atât. Este cel mai complex institut de cercetări medicale de la noi din țară și este aliniat cu cele mai prestigioase institute similare de pe continent.
Doar un mic exemplu ce întărește aceste vorbe: recent, cam cu o lună în urmă, premierul Mihai Tudose a dorit să vadă în scurt timp, cam în zece minute, ce se întâmplă în clădirea Oncogen. A intrat a văzut și a rămas atât de impresionat încât a prelungit vizita mai multe ore fiind covârșit de cele ce le afla la fața locului de la cercetători. Chiar a promis că va aloca mai multe resurse cercetării medicale ce se face aici.
În cel de-al doilea an de funcționare a centrului, OncoGen a demarat mai multe proiecte de cercetare cu finanţare europeană şi naţională. A organizat o serie de întâlniri şi conferinţe cu cercetători de prestigiu din Germania, Suedia, Austria, Franţa cât şi cu reprezentanţi ai mediului de afaceri din România, Germania, Austria şi SUA.
 În acest an sunt în derulare 2 proiecte din fonduri europene, în valoare de 4 milioane de euro în total. Adică câte două milioane pentru fiecare dintre ele. Acestea vizează dezvoltarea de imunoterapii personalizate, un domeniu foarte nou al cercetărilor medicale.
În acest an sunt în derulare 2 proiecte din fonduri europene, în valoare de 4 milioane de euro în total. Adică câte două milioane pentru fiecare dintre ele. Acestea vizează dezvoltarea de imunoterapii personalizate, un domeniu foarte nou al cercetărilor medicale.
Anul 2017 a reprezentat perioada în care, în cadrul ambelor proiecte, s-au realizat premiere nationale:
 Primul proiect este cel dedicat imunoterapiilor în cancer (CAR NK). S-a realizat, în premieră naţională, modelul experimental de tipărire 3D a tumorilor maligne şi implantarea acestora la şoareci modificaţi genetic. Acest model permite evaluarea eficienţei imunoterapiei personalizate cu celule natural killer, în perspectiva aplicării acestei terapii la om. Totodată s-a finalizat designul şi s-au derulat primele experimente de manipulare genetică a celulelor natural killer care pot recunoaşte şi distruge specific anumite tumori. În cadrul acestui proiect, 4 cercetători din grupul de lucru au fost în centrele partenere din Germania pentru validarea metodelor.
Primul proiect este cel dedicat imunoterapiilor în cancer (CAR NK). S-a realizat, în premieră naţională, modelul experimental de tipărire 3D a tumorilor maligne şi implantarea acestora la şoareci modificaţi genetic. Acest model permite evaluarea eficienţei imunoterapiei personalizate cu celule natural killer, în perspectiva aplicării acestei terapii la om. Totodată s-a finalizat designul şi s-au derulat primele experimente de manipulare genetică a celulelor natural killer care pot recunoaşte şi distruge specific anumite tumori. În cadrul acestui proiect, 4 cercetători din grupul de lucru au fost în centrele partenere din Germania pentru validarea metodelor.
Un al doilea proiect major este dedicat dezvoltării imunoterapiei specifice pentru pacienţii alergici la ambrozia (INSPIRED). În cadrul acestuia s-a realizat în premieră naţională producţia de alergene recombinate din polenul de ambrozia prin metode de inginerie genetică. În prezent, în centrul OncoGen sunt stocate primele 3 din cele 11 alergene cu impact în generarea reacţiei alergice la ambrozia. Validarea metodelor s-a realizat la centrul de cercetare partener din cadrul AKH Viena, de către 3 cercetători din grupul de lucru al proiectului.
 Tot în acest an a fost câștigat şi semnat proiectul strategic ROSECAN, un proiect strategic transfrontalier România-Serbia în valoare de 12 milioane de euro, care urmăreşte să ofere acces la servicii moderne şi eficiente de îngrijire medicală pentru toţi pacienţii oncologici din regiune, încurajând colaborarea dintre instituţiile medicale şi factorii de decizie din cele două ţări. Principala sarcină a Centrului OncoGen este de a dezvolta un program computerizat înalt performant dedicat diagnosticului personalizat în cancer, bazat pe secvenţializare genică.
Tot în acest an a fost câștigat şi semnat proiectul strategic ROSECAN, un proiect strategic transfrontalier România-Serbia în valoare de 12 milioane de euro, care urmăreşte să ofere acces la servicii moderne şi eficiente de îngrijire medicală pentru toţi pacienţii oncologici din regiune, încurajând colaborarea dintre instituţiile medicale şi factorii de decizie din cele două ţări. Principala sarcină a Centrului OncoGen este de a dezvolta un program computerizat înalt performant dedicat diagnosticului personalizat în cancer, bazat pe secvenţializare genică.
În cadrul proiectelor de cercetare pe fonduri naţionale pe direcţia dezvoltării de tehnologii avansate bazate pe imprimarea 3D, s-au validat metodele de producere de ţesuturi (cartilaj şi menisc) şi vase, cu potenţial de aplicare în medicină regenerativă precum şi metodele de producere de tumori maligne, cu potenţial de aplicare în medicina experimentală.
În cadrul proiectelor comunitare, s-a iniţiat primul studiu pilot de testare a riscului de cancer prin depistarea mutaţiilor genetice la persoanele cu risc familial.
În ultimul semestru al anului 2017 institutul Oncogen în parteneriat cu centre de cercetare din ţară și-a adjudecat două proiecte în cadrul competiţiei naţionale „Proiecte Complexe realizate în consorţii CDI” în valoare de 600.000 euro, unul în domeniul „Tehnologii noi şi emergente” şi unul în domeniul ,,Bioeconomie”.
În lumea tot mai globalizată în care continentul nostru va deveni în curând un mare sat lărgit nu se mai poate inchipui ca unii doctori să lucreze doar în cadrul colectivului lor fără a ști ce se intâmplă în jur. Colaborarea între Universități, chiar peste granițele tot mai subțiate, este o necesitate stringentă. Fondurile europene ce sunt destul de generoase se acordă cu prioritate colaborării transregionale și transfrontaliere.
În prezent specialiștii bănățeni sunt implicaţi într-un parteneriat cu Universitatea din Szeged în vederea aplicării unui proiect comun în cadrul Programului de Cooperare Transfrontalieră România – Ungaria 2018, având ca obiectiv creşterea calităţii serviciilor medicale dedicate femeilor afectate de infertilitate, gravidelor şi nou-născuţilor cu patologii infecţioase, precum şi identificarea celor mai comune specii microbiene la femeile simptomatice şi asimptomatice infertile din regiunea transfrontalieră.
Pentru colectivul OncoGen, 2017 a reprezentat anul în care s-au făcut angajări care au dus la consolidarea grupurilor de cercetare, fiind încheiate 60 de contracte de muncă, inclusiv cu cercetători proveniţi din străinătate, fapt care dovedeşte că un centru de cercetare modern, axat pe temele de cercetare de interes la nivel internaţional poate atrage oameni valoroşi, ducând la „câștigarea de creiere” şi la evitarea „pierderii de creiere” din ţară.
Misiunea centrului OncoGen este dezvoltarea de metode avansate de diagnostic şi tratament în cancer şi boli cronice cu incidenţă crescută (cu focus pe bolile alergice) precum şi dezvoltarea de terapii avansate în contextul medicinei regenerative, în paralel cu susţinerea de programe educaţionale şi parteneriate cu mediul academic şi cel industrial, pentru ca cercetarea medicală românească să devină competitivă la nivel internaţional şi să contribuie la dezvoltarea economică.
Mai în glumă sau poate destul de serios profesorul Virgil Păunescu „ameniță” că dacă și anul 2018 va fi la fel de bun nu vor mai avea loc pentru noile colective de cercetători și noile laboratoare. Vor fi nevoiți să mai adauge cel puțin încă un etaj clădirii Institutului.

Păcat că datorită demisiei Primului ministru Tudose sigur fondurile promise se vor volatiliza de conducerea partidelor politice care decid unde,când și sumele aferente…Și consider că nu este corect ca dacă vrei să faci un comentariu la subiectul în discuție să o poți face numai dacă te obliga banatulazi.ro să primesti ulterior mesaje sper pertinente…